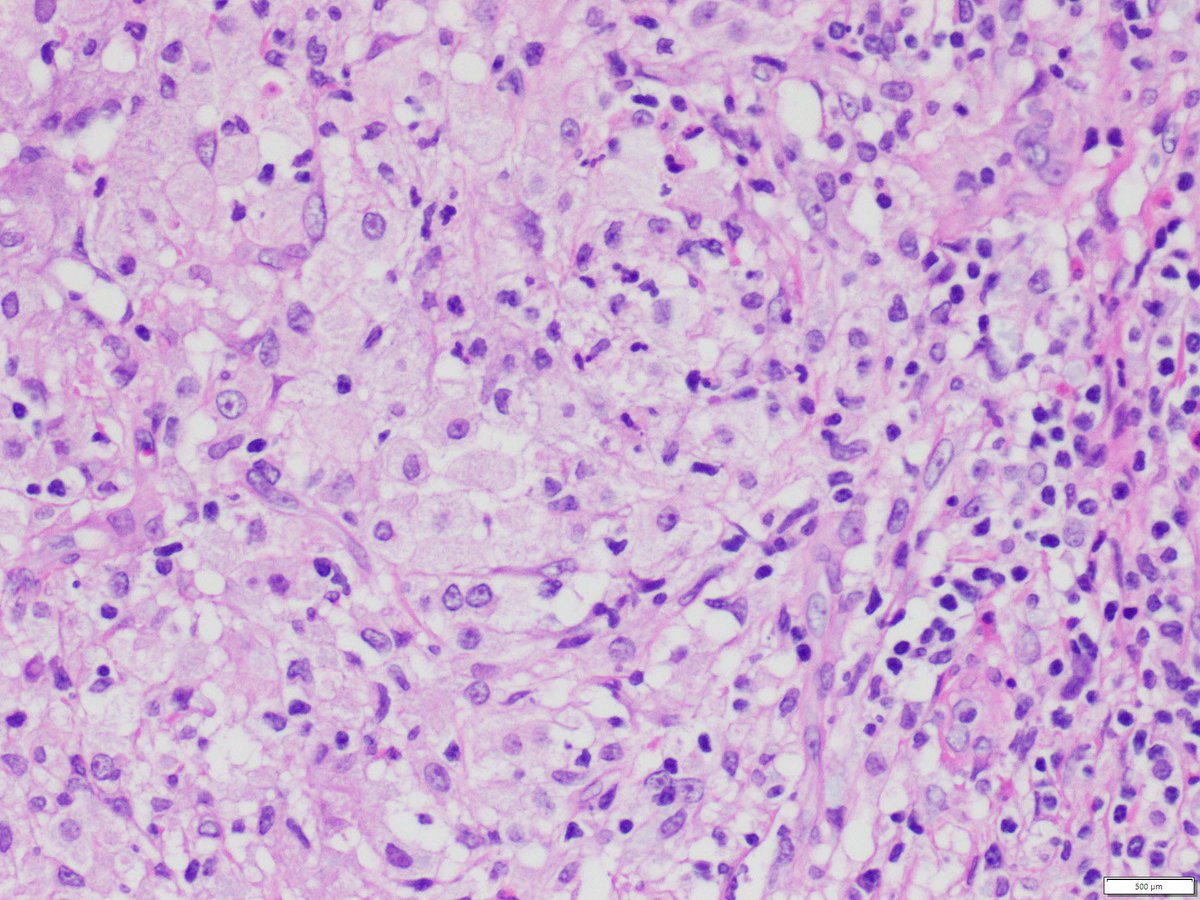

Tumor pathology
Кто носит папа
Новые игры 45
Лидеры первой русской революции
Химическая энергия в световую примеры
Приготовление куриной подливы
1с ка лизинг
Почему надо заряжать телефон
Что такое уход за телом
Сколько лет осталось до 2025 года
Заинтересован в своем здоровье
Particular anything
Пародия песни музыка
Чтение 2 класс учебник ответы 2025
Tumor pathology 112 фото